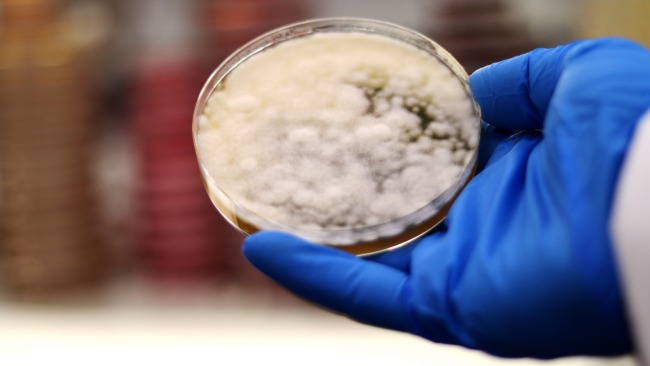

Publikacje: Kemin


Adsorption: How do binders act – the Bentonite example


What is in a mycotoxin binder, more than just "dirt": the science behind mycotoxin binders for pigs

Mycotoxins: The tax collectors


Mycotoxins in pigs: Hidden threats to health & performance


Respiratory Tract – how it is linked with the gut and stressors


Microbial Endocrinology: Beyond the Gut – Brain to gut axis communication


Reducing neurochemicals at a gut level as a tool to reduce infection


The overlooked component: Feed as a source of Neurochemicals


Microbial endocrinology: strategies to improve animal health
Kontakt:
Skontaktuj się z nami za pomocą poniższego formularza.